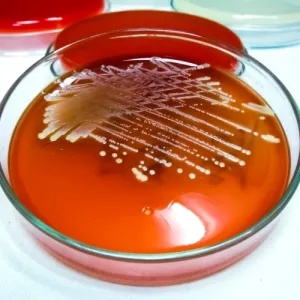
Ilustrační obrázek

Reportáže a rozhovory z odborných kongresů
Léčba atopické dermatitidy (AD) je u řady pacientů oříškem. Přestože mnohým z nich alespoň dočasně od svědění a viditelných projevů na kůži pomohou lokálně podávané krémy, u jiných tato terapie k udržení kontroly nad nemocí nestačí. Pro tyto případy je vhodná systémová léčba. Jednou z možností je abrocitinib. Jak účinkuje a jak si stojí ve srovnání s dupilumabem? Na tuto a mnohé další otázky odpovídají výsledky studie JADE DARE. A mluví jednoznačně ve prospěch perorálně podávaného abrocitinibu.

Zarudlé oblasti suché kůže provázené intenzivním svěděním – tak se projevuje AD na kůži pacienta. Nové léčivo abrocitinib, které se užívá v podobě jedné tablety jednou denně, zpomaluje imunitní odpověď organismu na určité stimuly, čímž omezuje rozvoj symptomů AD. Klinická studie JADE DARE se zaměřila na komparaci abrocitinibu s injekčně podávaným léčivem dupilumabem, které je taktéž schváleno pro léčbu AD. Probíhala po dobu 26 týdnů a kromě efektivity léčby zkoumala také bezpečnost přípravku.
Do studie JADE DARE bylo zařazeno celkem 727 pacientů léčených ve 151 centrech napříč 15 zeměmi. Nemocným bylo všem více než 18 let, s diagnózou AD se potýkali déle než půl roku, šlo o 397 mužů a 330 žen. Většina pacientů byla bílé rasy, Asiaté činili asi 20 % zařazených a asi 7 % účastníků bylo afroamerického původu. Pro zařazení do studie museli mít nemocní středně závažné až závažné projevy AD na více než 10 % povrchu těla a trpět významným pruritem. Po lokální léčbě trvající alespoň měsíc u nich nedošlo ke zlepšení potíží – a k tomuto selhání léčby muselo dojít dříve než 6 měsíců před zahájením studie. Pacienti, kteří byli již dříve léčeni pomocí dupilumabu nebo abrocitinibu, nesměli být do práce zařazeni.
Na začátku studie JADE DARE byli nemocní rozděleni do dvou skupin. Celkem 362 pacientů v té první obdrželo abrocitinib v dávce 200 mg každý den ve formě tablet a injekci placeba každé dva týdny. Ve druhé skupině, která obsahovala 365 pacientů, probíhala léčba injekčním dupilumabem, který byl aplikován subkutánně do stehna, břicha nebo paže. Pacienti současně dostávali každodenně pilulku placeba. Studie byla dvojitě zaslepená – ani nemocní, ani jejich lékaři nevěděli, kterou léčbu užívají. Kromě systémové terapie dostávali nemocní jednou denně lokální terapii ve formě krémů či mastí. Studie trvala 26 týdnů, nemocní byli následně sledováni ještě další čtyři týdny. V průběhu léčby i sledování byly posuzovány symptomy AD jako svědění, zarudnutí nebo suchá pokožka.
A jak to dopadlo? Po 14 dnech léčby došlo ke zlepšení pruritu u 9 z 20 pacientů (celkem u 172 z 357, tedy u 42 %) léčených abrocitinibem, ale jen u 5 z 20 (26 %) nemocných léčených dupilumabem. Po čtyřech týdnech léčby došlo k vymizení většiny projevů u 6 z 20 pacientů léčených abrocitinibem (29 %), ale jen u 3 z 20 nemocných léčených dupilumabem (15 %). Po 16 týdnech sledování bylo téměř úplné vymizení potíží pozorováno u 11 z 20 jedinců léčených abrocitinibem (54 %) a pouze u 8 z 20 pacientů (42 %) léčených dupilumabem. V případě abrocitinibu bylo po 26 týdnech pozorováno EASI-100 celkem u 22,7 %, u nemocných léčených dupilumabem se jednalo o pouze 13,9 %. Prvních sedm nemocných (1,9 %) léčených abrocitinibem dosáhlo EASI-100 již po dvou týdnech terapie, po čtyřech týdnech šlo již o 7,6 %, po osmi týdnech o 12,7 %. U dupilumabu takto výrazný nárůst pozorován nebyl. EASI-90 bylo po čtyřech týdnech léčby popsáno u 29 % pacientů léčených abrocitinibem, což je ve srovnání s 15 % u léčby dupilumabem taktéž zásadní rozdíl.
Při léčbě abrocitinibem různé nežádoucí příhody (AE) pozorovalo 15 ze 20 pacientů (74 %). Při terapii dupilumabem bylo číslo o něco nižší – 13 ze 20 (65 %). Mezi nejčastěji popisované potíže spadaly nauzea (19 % v případě abrocitinibu, 2 % u dupilumabu), bolest hlavy (13 % abrocitinib vs. 7 % dupilumab), akné (13 % abrocitinib vs. 3 % dupilumab) a konjunktivitida (3 % abrocitinib oproti 11 % na dupilumabu). Závažné nežádoucí příhody byly hlášeny u 6 nemocných v každé skupině (tedy 2 % na abrocitinibu a 2 % při léčbě dupilumabem). Ve skupině s abrocitinibem se konkrétně jednalo o pneumonii, infekci COVID-19 komplikovanou pneumonií, akutní cholecystitidu, zlomeninu paže, infekci COVID-19 vedoucí k úmrtí pacienta a infarkt myokardu s cévní mozkovou příhodou, který taktéž skončil smrtí. Všechny závažné nežádoucí příhody, které se vyskytly ve skupině s abrocitinibem, nebyly podle názoru zkoušejících spojeny hodnoceným léčivem. Závažné nežádoucí příhody ve skupině s dupilumabem zahrnovaly nefrotický syndrom, exacerbaci astmatu, muskuloskeletální bolesti na hrudi, rabdomyolýzu, zhoršení atopické dermatitidy a kritické zvýšení alaninaminotransferázy. Závažná nežádoucí příhoda rabdomyolýza ve skupině s dupilumabem byla zkoušejícím považována za pravděpodobně související s hodnoceným léčivem. U nemocných s nedostatečným efektem lokální léčby AD vedla obě dvě hodnocená systémová léčiva po 26 týdnech podávání k významnému zlepšení. Pacienti užívající abrocitinib ovšem dosahovali podstatně lepších výsledků, než nemocní na léčbě dupilumabem – na léčbu reagovali dříve a ve vyšších počtech. Abrocitinib byl efektivnější v úlevě od pruritu a častěji vedl ke kompletnímu nebo téměř kompletnímu vymizení projevů.
U nemocných s nedostatečným efektem lokální léčby AD obě dvě zkoumaná systémová léčiva vedla po 26 týdnech podávání k významnému zlepšení. Pacienti užívající abrocitinib však dosahovali podstatně lepších výsledků než nemocní léčení dupilumabem – na léčbu reagovali dříve a ve vyšších počtech. Abrocitinib byl efektivnější v úlevě od pruritu a častěji vedl ke kompletnímu nebo téměř kompletnímu vymizení projevů.
Studie JADE DARE tedy jednoznačně prokázala, že abrocitinib podávaný perorálně v dávce 200 mg/den je v léčbě středně závažné až závažné AD u dospělých pacientů efektivnější a srovnatelně bezpečný jako injekční léčba dupilumabem. U některých pacientů vedl abrocitinib již po dvou týdnech terapie k dosažení EASI-100 a po 26 týdnech léčení díky němu dosáhlo EASI-100 více než 20 % nemocných, což je signifikantně lepší výsledek než při terapii pomocí dupilumabu. Léčba abrocitinibem i dupilumabem byla dobře snášena, s povětšinou nezávažnými a dobře ovlivnitelnými nežádoucími příhodami, které nezhoršovaly kvalitu života.
(red)
Zdroje:

Reportáže a rozhovory z odborných kongresů
Opouštíte prostředí společnosti Pfizer, spol. s r. o.
Společnost Pfizer, spol. s r. o., neručí za obsah stránek, které hodláte navštívit.
Přejete si pokračovat?